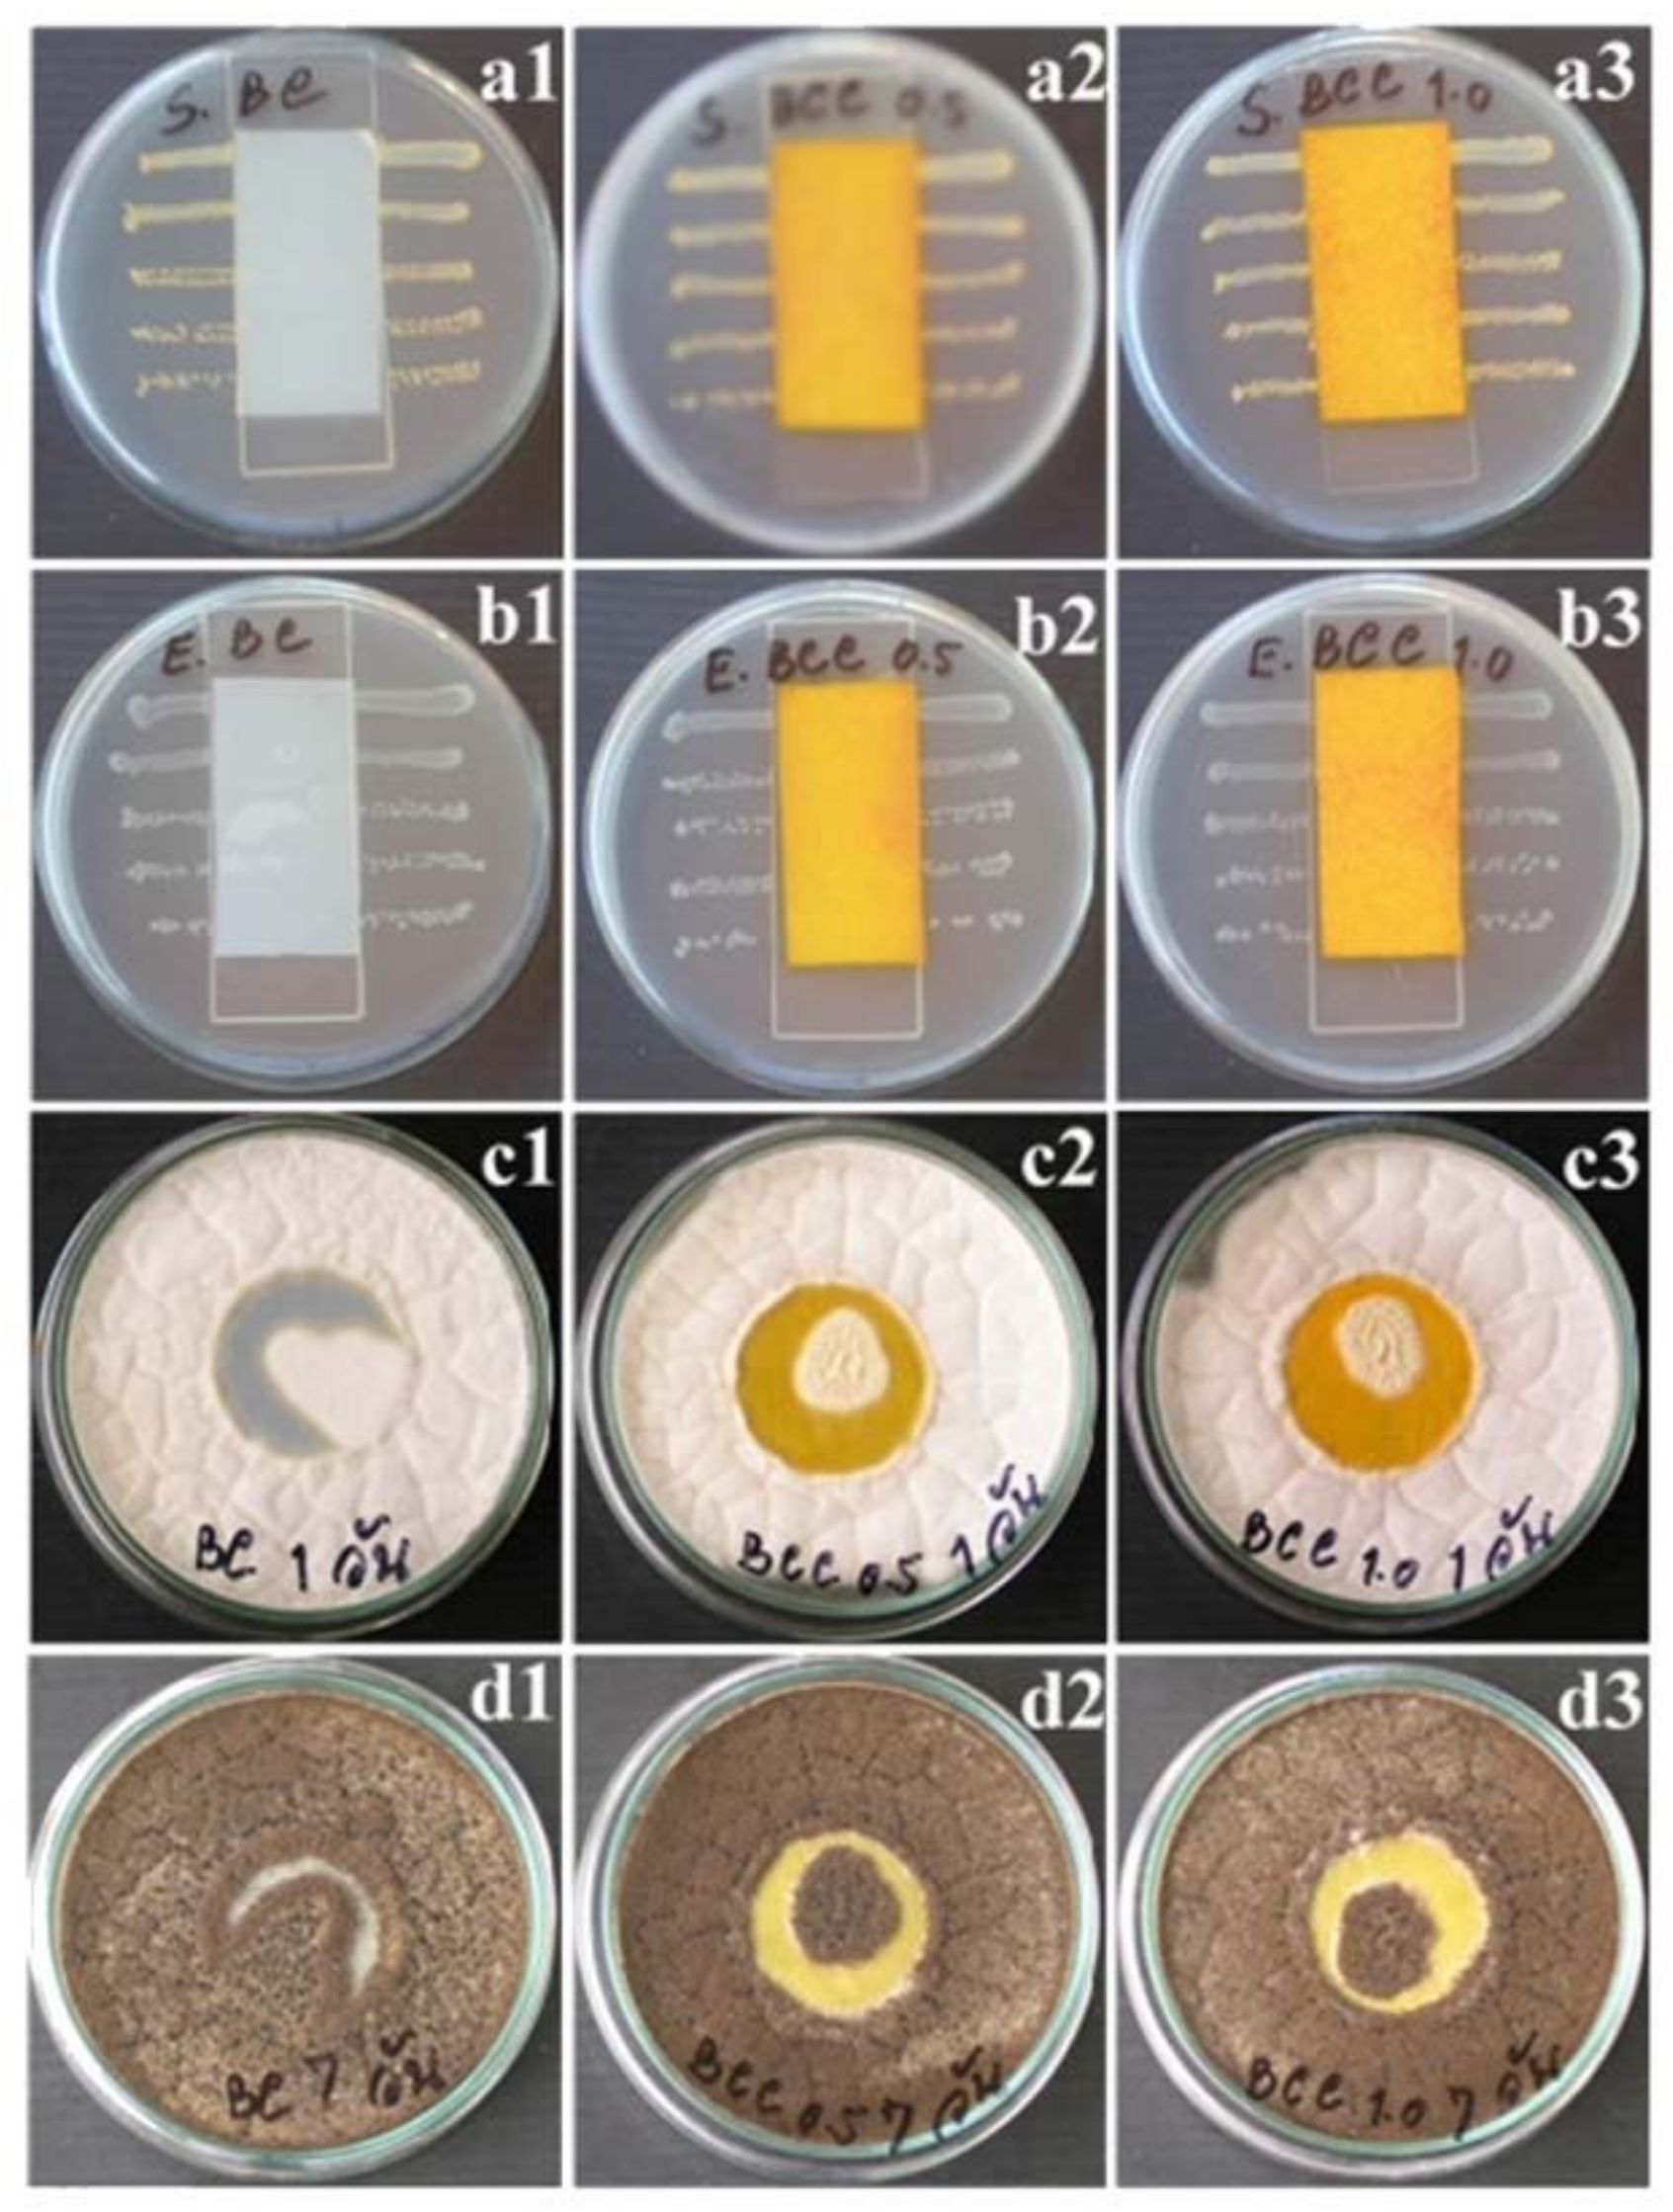
Applsci 08 01188 g006 Applsci 08 01188 g006

Characteristics of Curcumin-Loaded Bacterial Cellulose Films and Anticancer Properties against Malignant Melanoma Skin Cancer Cells
Abstract
1. Introduction
2. Materials and Methods
2.1. Materials
2.2. Cells, Microbial, and Fungal Strains
2.3. Preparation of Curcumin-Loaded BC Film
2.4. Curcumin Content Analysis
2.5. Characterization of Curcumin-Loaded BC Films
2.6. In Vitro Release Assay
2.7. Antimicrobial Property Assessment
2.8. Measurement of Anticancer Properties
3. Results and Discussion
3.1. Absorption of Curcumin into BC
3.2. Characterization of BC-Curcumin Membrane
3.2.1. Surface and Surface and Cross-Sectional Morphologies
3.2.2. Gas Permeability Test
3.2.3. FTIR Analysis
3.2.4. Mechanical Properties
3.3. Release Assay
3.4. Antibacterial and Antifungal Properties
3.5. Cytotoxicity and Anticancer Properties
4. Conclusions
Author Contributions
Acknowledgments
Conflicts of Interest
References
- Jedrzejczak-Krzepkowska, M.; Kubiak, K.; Ludwicka, K.; Bielecki, S. Bacterial nanocellulose synthesis, recent findings. In Bacterial Cellulose from Biotechnology to Bio-Economy; Elsevier: Amsterdam, The Netherlands, 2016; pp. 19–46. [Google Scholar]
- Watanabe, K.; Tabuchi, M.; Morinaga, Y.; Yoshinaga, F. Structural features and properties of bacterial cellulose produced in agitated culture. Cellulose 1998, 5, 187–200. [Google Scholar] [CrossRef]
- Helenius, G.; Bäckdahl, H.; Bodin, A.; Nannmark, U.; Gatenholm, P.; Risberg, B. In vivo biocompatibility of bacterial cellulose. J. Biomed. Mater. Res. A 2006, 76, 431–438. [Google Scholar] [CrossRef] [PubMed]
- Svensson, A.; Nicklasson, E.; Harrah, T.; Panilaitis, B.; Kaplan, D.L.; Brittberg, M.; Gatenholm, P. Bacterial cellulose as a potential scaffold for tissue engineering of cartilage. Biomaterials 2005, 26, 419–431. [Google Scholar] [CrossRef] [PubMed]
- Klemm, D.; Schumann, D.; Udhardt, U.; Marsch, S. Bacterial synthesized cellulose—Artificial blood vessels for microsurgery. Prog. Polym. Sci. 2001, 26, 1561–1603. [Google Scholar] [CrossRef]
- Fontana, J.; De Souza, A.; Fontana, C.; Torriani, I.; Moreschi, J.; Gallotti, B.; De Souza, S.; Narcisco, G.; Bichara, J.; Farah, L. Acetobacter cellulose pellicle as a temporary skin substitute. Appl. Biochem. Biotechnol. 1990, 24–25, 253–264. [Google Scholar] [CrossRef] [PubMed]
- Czaja, W.; Krystynowicz, A.; Bielecki, S.; Brown, R.M., Jr. Microbial cellulose—The natural power to heal wounds. Biomaterials 2006, 27, 145–151. [Google Scholar] [CrossRef] [PubMed]
- Numata, Y.; Mazzarino, L.; Borsali, R. A slow-release system of bacterial cellulose gel and nanoparticles for hydrophobic active ingredients. Int. J. Pharm. 2015, 486, 217–225. [Google Scholar] [CrossRef] [PubMed]
- Langer, R. Biomaterials for drug delivery and tissue engineering. MRS Bull. 2006, 31, 477–485. [Google Scholar] [CrossRef]
- De Olyveira, G.M.; Costa, L.M.M.; Basmaji, P. Physically modified bacterial cellulose as alternative routes for transdermal drug delivery. J. Biomater. Tissue Eng. 2013, 3, 227–232. [Google Scholar] [CrossRef]
- Stoica-Guzun, A.; Stroescu, M.; Tache, F.; Zaharescu, T.; Grosu, E. Effect of electron beam irradiation on bacterial cellulose membranes used as transdermal drug delivery systems. Nucl. Instrum. Methods Phys. Res. Sect. B Beam Interact. Mater. At. 2007, 265, 434–438. [Google Scholar] [CrossRef]
- Taokaew, S.; Nunkaew, N.; Siripong, P.; Phisalaphong, M. Characteristics and anticancer properties of bacterial cellulose films containing ethanolic extract of mangosteen peel. J. Biomater. Sci. Polym. Ed. 2014, 25, 907–922. [Google Scholar] [CrossRef] [PubMed]
- Koh, H.K.; Geller, A.C.; Miller, D.R.; Grossbart, T.A.; Lew, R.A. Prevention and early detection strategies for melanoma and skin cancer. Arch. Dermatol. 1996, 132, 436–443. [Google Scholar] [CrossRef] [PubMed]
- Chummun, S.; McLean, N.R. The management of malignant skin cancers. Surgery 2014, 32, 485–490. [Google Scholar] [CrossRef]
- Gordon, R. Skin cancer: An overview of epidemiology and risk factors. Semin. Oncol. Nurs. 2013, 29, 160–169. [Google Scholar] [CrossRef] [PubMed]
- Sandur, S.K.; Pandey, M.K.; Sung, B.; Ahn, K.S.; Murakami, A.; Sethi, G.; Limtrakul, P.; Badmaev, V.; Aggarwal, B.B. Curcumin, demethoxycurcumin, bisdemethoxycurcumin, tetrahydrocurcumin and turmerones differentially regulate anti-inflammatory and anti-proliferative responses through a ROS-independent mechanism. Carcinogenesis 2007, 28, 1765–1773. [Google Scholar] [CrossRef] [PubMed]
- Ahsan, H.; Parveen, N.; Khan, N.U.; Hadi, S.M. Pro-oxidant, anti-oxidant and cleavage activities on DNA of curcumin and its derivatives demethoxycurcumin and bisdemethoxycurcumin. Chem. Biol. Interact. 1999, 121, 161–175. [Google Scholar] [CrossRef]
- Goel, A.; Kunnumakkara, A.B.; Aggarwal, B.B. Curcumin as “curecumin”: From kitchen to clinic. Biochem. Pharmacol. 2008, 75, 787–809. [Google Scholar] [CrossRef] [PubMed]
- Chen, B.; Zhang, Y.; Wang, Y.; Rao, J.; Jiang, X.; Xu, Z. Curcumin inhibits proliferation of breast cancer cells through nrf2-mediated down-regulation of fen1 expression. J. Steroid Biochem. Mol. Biol. 2014, 143, 11–18. [Google Scholar] [CrossRef] [PubMed]
- Liu, D.; Chen, Z. The effect of curcumin on breast cancer cells. J. Breast Cancer 2013, 16, 133–137. [Google Scholar] [CrossRef] [PubMed]
- Xu, X.; Qin, J.; Liu, W. Curcumin inhibits the invasion of thyroid cancer cells via down-regulation of pi3k/akt signaling pathway. Gene 2014, 546, 226–232. [Google Scholar] [CrossRef] [PubMed]
- Zhang, C.Y.; Zhang, L.; Yu, H.X.; Bao, J.D.; Sun, Z.; Lu, R.R. Curcumin inhibits invasion and metastasis in k1 papillary thyroid cancer cells. Food Chem. 2013, 139, 1021–1028. [Google Scholar] [CrossRef] [PubMed]
- Watson, J.L.; Hill, R.; Lee, P.W.; Giacomantonio, C.A.; Hoskin, D.W. Curcumin induces apoptosis in hct-116 human colon cancer cells in a p21-independent manner. Exp. Mol. Pathol. 2008, 84, 230–233. [Google Scholar] [CrossRef] [PubMed]
- Shakor, A.B.; Atia, M.; Ismail, I.A.; Alshehri, A.; El-Refaey, H.; Kwiatkowska, K.; Sobota, A. Curcumin induces apoptosis of multidrug-resistant human leukemia hl60 cells by complex pathways leading to ceramide accumulation. Biochim. Biophys. Acta 2014, 1841, 1672–1682. [Google Scholar] [CrossRef] [PubMed]
- Yosifov, D.Y.; Kaloyanov, K.A.; Guenova, M.L.; Prisadashka, K.; Balabanova, M.B.; Berger, M.R.; Konstantinov, S.M. Alkylphosphocholines and curcumin induce programmed cell death in cutaneous t-cell lymphoma cell lines. Leuk. Res. 2014, 38, 49–56. [Google Scholar] [CrossRef] [PubMed]
- Sha, J.; Li, J.; Wang, W.; Pan, L.; Cheng, J.; Li, L.; Zhao, H.; Lin, W. Curcumin induces g0/g1 arrest and apoptosis in hormone independent prostate cancer du-145 cells by down regulating notch signaling. Biomed. Pharmacother. 2016, 84, 177–184. [Google Scholar] [CrossRef] [PubMed]
- Lev-Ari, S.; Starr, A.; Katzburg, S.; Berkovich, L.; Rimmon, A.; Ben-Yosef, R.; Vexler, A.; Ron, I.; Earon, G. Curcumin induces apoptosis and inhibits growth of orthotopic human non-small cell lung cancer xenografts. J. Nutr. Biochem. 2014, 25, 843–850. [Google Scholar] [CrossRef] [PubMed]
- Seo, J.A.; Kim, B.; Dhanasekaran, D.N.; Tsang, B.K.; Song, Y.S. Curcumin induces apoptosis by inhibiting sarco/endoplasmic reticulum ca2+ atpase activity in ovarian cancer cells. Cancer Lett. 2016, 371, 30–37. [Google Scholar] [CrossRef] [PubMed]
- Ma, J.; Fang, B.; Zeng, F.; Pang, H.; Zhang, J.; Shi, Y.; Wu, X.; Cheng, L.; Ma, C.; Xia, J.; et al. Curcumin inhibits cell growth and invasion through up-regulation of mir-7 in pancreatic cancer cells. Toxicol. Lett. 2014, 231, 82–91. [Google Scholar] [CrossRef] [PubMed]
- Zhang, Y.P.; Li, Y.Q.; Lv, Y.T.; Wang, J.M. Effect of curcumin on the proliferation, apoptosis, migration, and invasion of human melanoma a375 cells. Genet. Mol. Res. 2015, 14, 1056–1067. [Google Scholar] [CrossRef] [PubMed]
- Shoba, G.; Joy, D.; Joseph, T.; Majeed, M.; Rajendran, R.; Srinivas, P.S.S.R. Influence of piperine on the pharmacokinetics of curcumin in animals and human volunteers. Planta Med. 1998, 64, 353–356. [Google Scholar] [CrossRef] [PubMed]
- Sooklert, K.; Ngambenjawong, C.; Iempridee, T.; Rojanathanes, R.; Pushpitha, M.T.K.; Sereemaspun, A. Gold nanoparticle-colocasia gigantea mixture for enhancing cytotoxic effect against a375 melanoma cell line. Thai J. Pharm. Sci. 2017, 41, 130–137. [Google Scholar]
- Taokaew, S.; Phisalaphong, M.; Newby, B.M.Z. Bacterial cellulose: Biosyntheses, modifications, and applications. In Applied Environmental Materials Science for Sustainability; IGI Global: Hershey, PA, USA, 2016; pp. 255–283. [Google Scholar]
- Wu, P.; Fisher, A.C.; Foo, P.P.; Queen, D.; Gaylor, J.D.S. In vitro assessment of water vapour transmission of synthetic wound dressings. Biomaterials 1995, 16, 171–175. [Google Scholar] [CrossRef]
- Ruiz-Cardona, L.; Sanzgiri, Y.D.; Benedetti, L.M.; Stella, V.J.; Topp, E.M. Application of benzyl hyaluronate membranes as potential wound dressings: Evaluation of water vapour and gas permeabilities. Biomaterials 1996, 17, 1639–1643. [Google Scholar] [CrossRef]
- Wu, P.; Nelson, E.A.; Reid, W.H.; Ruckley, C.V.; Gaylor, J.D.S. Water vapour transmission rates in burns and chronic leg ulcers: Influence of wound dressings and comparison with in vitro evaluation. Biomaterials 1996, 17, 1373–1377. [Google Scholar] [CrossRef]
- Chidambaram, M.; Krishnasamy, K. Drug-drug/drug-excipient compatibility studies on curcumin using non-thermal methods. Adv. Pharm. Bull. 2014, 4, 309–312. [Google Scholar] [PubMed]
- Li, C.; Luo, T.; Zheng, Z.; Murphy, A.R.; Wang, X.; Kaplan, D.L. Curcumin-functionalized silk materials for enhancing adipogenic differentiation of bone marrow-derived human mesenchymal stem cells. Acta Biomater. 2015, 11, 222–232. [Google Scholar] [CrossRef] [PubMed]
- Kharat, M.; Du, Z.; Zhang, G.; McClements, D.J. Physical and chemical stability of curcumin in aqueous solutions and emulsions: Impact of pH, temperature, and molecular environment. J. Agric. Food Chem. 2017, 65, 1525–1532. [Google Scholar] [CrossRef] [PubMed]
- Kingkaew, J.; Kirdponpattara, S.; Sanchavanakit, N.; Pavasant, P.; Phisalaphong, M. Effect of molecular weight of chitosan on antimicrobial properties and tissue compatibility of chitosan-impregnated bacterial cellulose films. Biotechnol. Bioprocess. Eng. 2014, 19, 534–544. [Google Scholar] [CrossRef]
- Wang, Y.; Lu, Z.; Wu, H.; Lv, F. Study on the antibiotic activity of microcapsule curcumin against foodborne pathogens. Int. J. Food Microbiol. 2009, 136, 71–74. [Google Scholar] [CrossRef] [PubMed]
- Mun, S.H.; Joung, D.K.; Kim, Y.S.; Kang, O.H.; Kim, S.B.; Seo, Y.S.; Kim, Y.C.; Lee, D.S.; Shin, D.W.; Kweon, K.T.; et al. Synergistic antibacterial effect of curcumin against methicillin-resistant staphylococcus aureus. Phytomedicine 2013, 20, 714–718. [Google Scholar] [CrossRef] [PubMed]
- Hogt, A.H.; Dankert, J.; Feijen, J. Adhesion of coagulase-negative staphylococci to methacrylate polymers and copolymers. J. Biomed. Mater. Res. 1986, 20, 533–545. [Google Scholar] [CrossRef] [PubMed]
- Agarwal, A.; Kasinathan, A.; Ganesan, R.; Balasubramanian, A.; Bhaskaran, J.; Suresh, S.; Srinivasan, R.; Aravind, K.B.; Sivalingam, N. Curcumin induces apoptosis and cell cycle arrest via the activation of reactive oxygen species–independent mitochondrial apoptotic pathway in smad4 and p53 mutated colon adenocarcinoma ht29 cells. Nutr. Res. 2018, 51, 67–81. [Google Scholar] [CrossRef] [PubMed]
- Ebrahimifar, M.; Hasanzadegan Roudsari, M.; Kazemi, S.M.; Ebrahimi Shahmabadi, H.; Kanaani, L.; Alavi, S.A.; Izadi Vasfi, M. Enhancing effects of curcumin on cytotoxicity of paclitaxel, methotrexate and vincristine in gastric cancer cells. Asian Pac. J. Cancer Prev. 2017, 18, 65–68. [Google Scholar] [PubMed]
- Jee, S.H.; Shen, S.C.; Tseng, C.R.; Chiu, H.C.; Kuo, M.L. Curcumin induces a p53-dependent apoptosis in human basal cell carcinoma cells. J. Invest. Dermatol. 1998, 111, 656–661. [Google Scholar] [CrossRef] [PubMed]
- Sa, G.; Das, T. Anti cancer effects of curcumin: Cycle of life and death. Cell. Div. 2008, 3, 14. [Google Scholar] [CrossRef] [PubMed]

| Film | WVTR (g/m2/day) | OTR (cm3/m2/day) |
|---|---|---|
| BC | 597.3 ± 90.5 | 2.24 ± 0.15 |
| BCC0.2 | 481.6 ± 35.1 | 1.26 ± 0.01 |
| BCC0.8 | 434.8 ± 185.6 | 1.13 ± 0.16 |
| BCC1.0 | 506.2 ± 89.7 | 0.70 ± 0.05 |
© 2018 by the authors. Licensee MDPI, Basel, Switzerland. This article is an open access article distributed under the terms and conditions of the Creative Commons Attribution (CC BY) license (http://creativecommons.org/licenses/by/4.0/).
Share and Cite
Subtaweesin, C.; Woraharn, W.; Taokaew, S.; Chiaoprakobkij, N.; Sereemaspun, A.; Phisalaphong, M. Characteristics of Curcumin-Loaded Bacterial Cellulose Films and Anticancer Properties against Malignant Melanoma Skin Cancer Cells. Appl. Sci. 2018, 8, 1188. https://doi.org/10.3390/app8071188
Subtaweesin C, Woraharn W, Taokaew S, Chiaoprakobkij N, Sereemaspun A, Phisalaphong M. Characteristics of Curcumin-Loaded Bacterial Cellulose Films and Anticancer Properties against Malignant Melanoma Skin Cancer Cells. Applied Sciences. 2018; 8(7):1188. https://doi.org/10.3390/app8071188
Chicago/Turabian StyleSubtaweesin, Chayut, Wannipa Woraharn, Siriporn Taokaew, Nadda Chiaoprakobkij, Amornpun Sereemaspun, and Muenduen Phisalaphong. 2018. "Characteristics of Curcumin-Loaded Bacterial Cellulose Films and Anticancer Properties against Malignant Melanoma Skin Cancer Cells" Applied Sciences 8, no. 7: 1188. https://doi.org/10.3390/app8071188
APA StyleSubtaweesin, C., Woraharn, W., Taokaew, S., Chiaoprakobkij, N., Sereemaspun, A., & Phisalaphong, M. (2018). Characteristics of Curcumin-Loaded Bacterial Cellulose Films and Anticancer Properties against Malignant Melanoma Skin Cancer Cells. Applied Sciences, 8(7), 1188. https://doi.org/10.3390/app8071188
